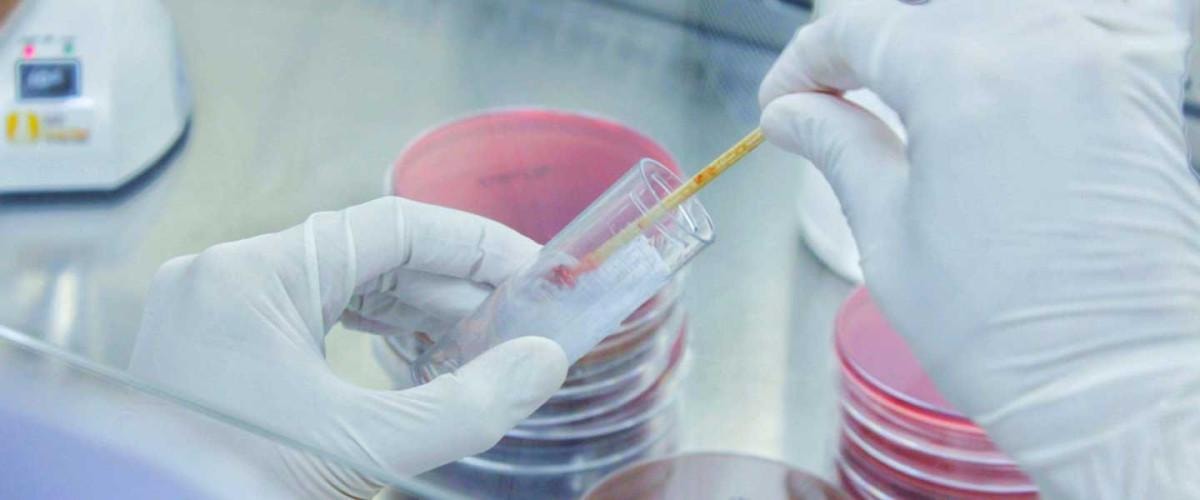

Öksürük ile birlikte dışarı atılan bir mukus çeşidi olan balgam çoğu durumda oldukça can sıkıcı olan durumların başında yer alır.
Solunum yollarında oluşan bu mukusun öksürükle dışarı atılması ya da ilaçlar yardımıyla dışarı atılması gerekir.
Vücudumuzun hastalıklar konusunda verdiği ipuçlarında biri de balgam renginizden ortaya çıkıyormuş. Meğer her balgam sandığınız kadar masum değilmiş.

BALGAM RENKLERİ VE ANLAMLARI
Şeffaf veya beyaz renkli balgam
Şeffaf veya beyaz balgam genellikle sağlıklı bir solunum sisteminin işaretidir. Ancak, aşırı miktarda beyaz balgam üretimi, soğuk algınlığı, alerji veya viral enfeksiyonlar gibi durumların belirtisi olabilir. Bu tür balgam genellikle solunum yollarında iltihaplanma olmadığını gösterir.
Sari veya yeşil renkli balgam
Sarı veya yeşil balgam, vücudun enfeksiyonla mücadele ettiğini gösterir. Bu renk değişikliği, beyaz kan hücrelerinin enfeksiyon bölgesine akın etmesiyle oluşur.
Sarı balgam genellikle başlangıç aşamasındaki bir enfeksiyonu işaret ederken, yeşil balgam daha ciddi veya ilerlemiş bir enfeksiyona işaret edebilir. Sinüzit, bronşit veya zatürre gibi bakteriyel enfeksiyonlar bu tür balgam üretimine neden olabilir.
Kırmızı veya kahverengi balgam
Kahverengi veya kırmızı balgam, solunum yollarında kanama olduğunu gösterebilir. Kahverengi balgam, eski kanın varlığını işaret ederken, kırmızı balgam taze kanın varlığını gösterir. Bu durum, akciğer kanseri, tüberküloz, pulmoner emboli veya ciddi bronşit gibi ciddi sağlık sorunlarının belirtisi olabilir. Bu tür balgam üretimi durumunda derhal bir doktora başvurulmalıdır.
Siyah renkli balgam
Siyah balgam, genellikle kömür, toz veya sigara dumanı gibi maddelerin solunması sonucu oluşur. Madenciler veya sigara içenler arasında yaygın olarak görülebilir. Siyah balgam, ayrıca mantar enfeksiyonlarının da belirtisi olabilir. Bu tür balgam üretimi, solunum yollarında ciddi bir sorunun işareti olabilir ve tıbbi müdahale gerektirebilir.
Pembe veya köpüklü balgam rengi
Pembe veya köpüklü balgam, genellikle akciğer ödemi gibi ciddi bir durumun belirtisidir. Akciğer ödemi, akciğerlerde sıvı birikmesi sonucu oluşur ve kalp yetmezliği gibi durumlarla ilişkilidir. Bu tür balgam üretimi acil tıbbi müdahale gerektirir.